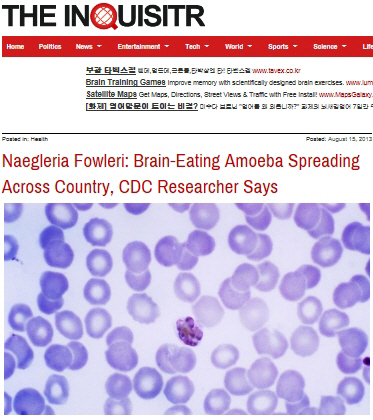

뇌를 파 먹는 기생충에 감염되는 일이 잇따라 벌어져 충격을 주고 있다.
15일(현지시간) 인터넷매체 인쿼지터에 따르면 지난달 미국 아칸소주에서 뇌를 파 먹는 아메바인 '네글레리아 파울러리'에 감염된 12세 소녀에 이어 플로리다주에 거주하는 12세 소년도 감염된 것으로 밝혀졌다.
앞서 감염된 소녀는 워터파크에서 물놀이를 하고 돌아온 뒤 두통과 고열에 시달렸으며, 소년은 집 근처 도랑에서 무릎을 꿇은 채 보드를 타는 '니보딩'을 한 뒤 다음날까지 오랫동안 잠을 잔 것으로 알려졌다.
의료진은 뇌검사 등을 토대로 두 소년소녀가 뇌를 파 먹는 아메바에 감염된 사실을 확인했다.
미국 질병통제예방센터 등 보건 당국은 치사율이 94%에 이르는 네글레리아 파울러리 감염환자가 연이어 발생하자 긴장하는 모습이다.
하지만 다행인 것은 앞서 감염된 12세 소녀가 회복중인 것으로 전해져 치료법에 주목하고 있다.
보건당국 관계자는 "네글레리아 파울러리의 경우 온천이나 따뜻한 민물 등에서 자주 발견되며 사람의 코를 통해 몸 속으로 들어가 뇌 속을 돌아다닌다"고 말했다. 또한 "감염된지 1주일 후부터 두통과 고열, 메스꺼움, 구토, 목이 뻣뻣해지는 등의 증상이 나타난다"고 설명했다.
그는 "감염 예방을 위해 수온이 높은 민물에서 수영을 피하고 수영을 할때는 코를 막을 수 있는 기구 등을 사용해야 한다"고 당부했다.
한편, 지난해 파키스탄에서도 이 아메바에 감염된 환자 10명이 사망했다.
[소비자인사이트/스포츠조선] 장종호기자 bellho@sportschosun.com